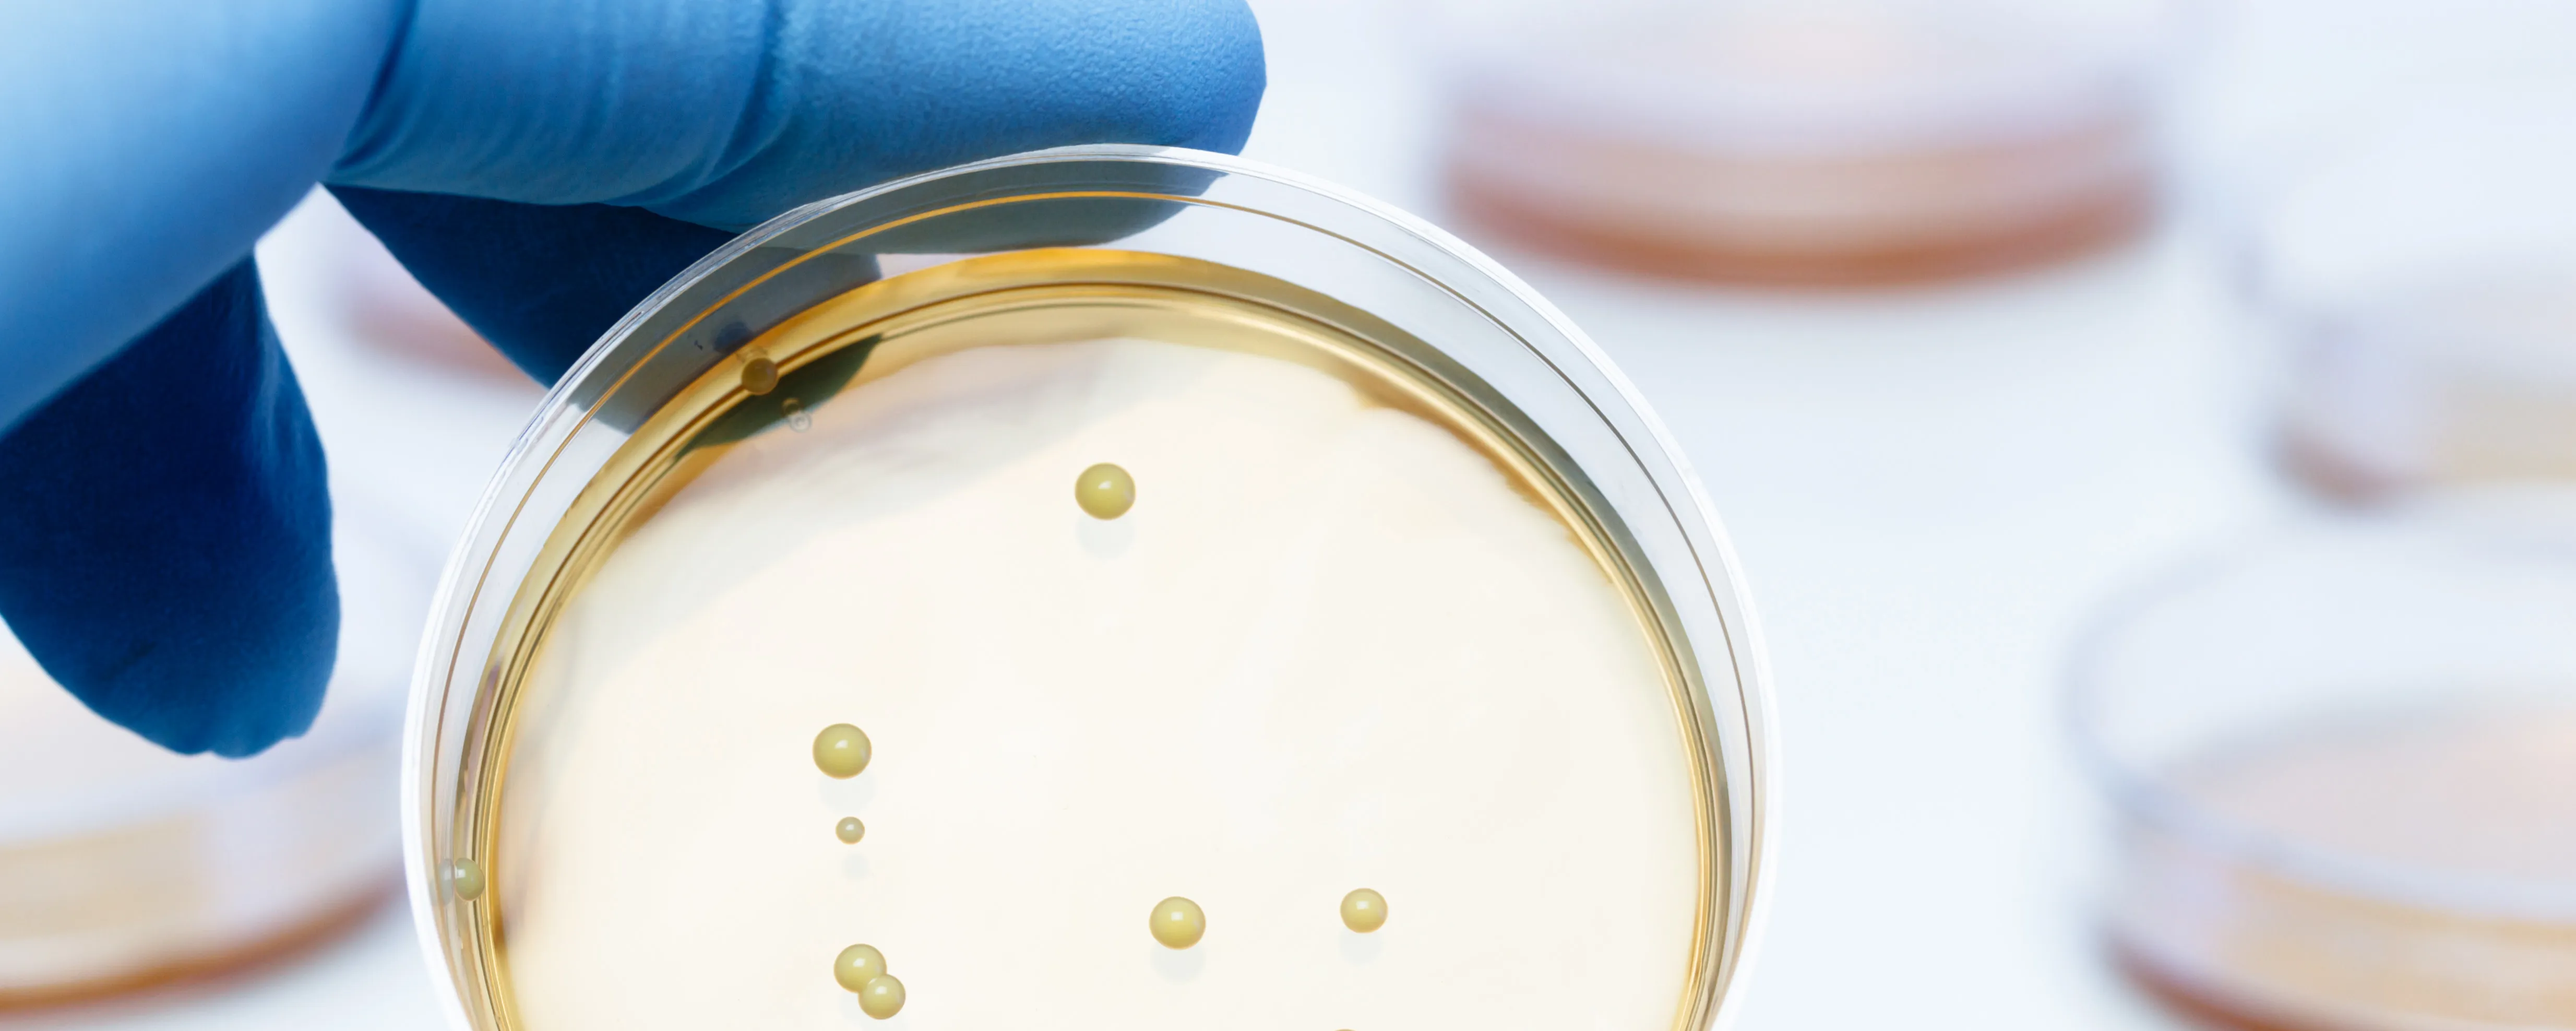
Effective Reliable Strain - Front Page Image 720X530

Meet us at HNC Expo in Shanghai, June 15-17! Welcome to our booth 3F45 in Hall 3 which we will be sharing with our distributor CNP.
We are proud to contribute to the scientific programme at the 19th International Scientific Conference on Probiotics, Prebiotics, Gut Microbiota and Health (IPC 2026) in Kraków, Poland, June 22–24.
When selecting a probiotic strain for your product, you must know how to differentiate between bacteria. Bacteria are classified into different groups according to traits. The bacteria family tree has several hierarchical levels, starting with Kingdom (Bacteria) followed by Phylum, where bacteria are ordered into 24 divisions. The most common divisions for probiotic bacteria are “Firmicutes” (for example, Lactobacilli) or “Actinobacteria” (such as Bifidobacteria), whereas many typically pathogenic bacteria belong to the phylum of “Proteobacteria” (like, Salmonella).
The further down the family tree, the higher the similarity between bacteria. The last three parts of the hierarchy, Genus – Species – Strains, are most often the ones discussed for probiotic strains.

Lactobacillus is a genus composed of many different species including Lactiplantibacillus plantarum*. Each species contains several strains. For example, Lactiplantibacillus plantarum 299v and Lactiplantibacillus plantarum HEAL9 are different strains of the same species (and genus). Some proprietary strains also have a trademark, such as LP299V®. An individual bacterial strain is defined as genetically identical cells, sharing the same traits.
Another important aspect when selecting the right probiotic strain is to know the strain’s origin. Probiotic bacteria can originate from many different places, including plants, vegetables, food products and animal or human microbiota. Human origin is often viewed as important for possible colonization in the gastrointestinal tract of that particular strain after consumption. This can however not be guaranteed without performing clinical studies investigating colonization and persistence within the gut.
There are several different criteria to be considered when producing a probiotic product. Probi has more than 30 years of experience working in the field of probiotics. Contact us to learn more about how we can support your company all the way from strain selection to finished product.

Image: A microscopic picture of Lactiplantibacillus plantarum 299v (LP299V®).
Bacteria can have three different shapes; Spheres (as Streptococci), Rods (as LP299V® in the picture) and Spirals (as Helicobacter).
* changed from Lactobacillus plantarum in the 2020 taxonomy-changes.

We know probiotics are living bacteria, but in reality, they’re more. Find out what it takes to be a probiotic.

Learn how our probiotic concept Probi Digestis® works and supports gastrointestinal health.

The most documented L. plantarum strain in the world, related to gut health. LP299V® probiotic strain is suitable for dietary...